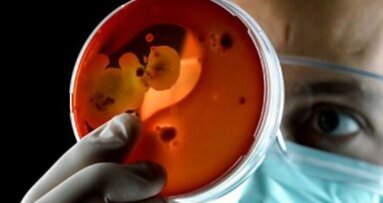
Streptococco, i consigli degli esperti

Dental Tribune intervista Aldo Bruno Giannì, Giovanna Perrotti e Tiziano Testori.
Prof. Aldo Bruno Giannì, direttore dell’Unità operativa complessa di Chirurgia maxillo-facciale e Odontostomatologia presso la Fondazione Ca’ Granda - Ospedale Policlinico di Milano.
Professor Giannì, ci può parlare dell’approccio facciale globale? Ci può illustrare cosa si intende con questo termine?
Innanzitutto vorrei chiarire che il concetto non è una novità in senso assoluto, ma è un approccio che potremmo definire globale di riabilitazione sia funzionale che estetica non solo della bocca, ma del viso in toto. Tale filosofia – cioè l’ottimizzazione del risultato estetico e funzionale – è un obiettivo consolidato da molti anni in svariati ambiti della chirurgia maxillo-facciale. In particolare, parlando di chirurgia ortognatica, la semplice correzione dei rapporti occlusali in paziente con deformità dento-mascellare oggi non è più accettabile. Infatti, per definizione l’obiettivo è quello di ottenere sì una correzione di rapporti occlusali, ma nel contempo anche la migliore estetica del viso con un armonico rapporti tra le tre componenti, che sempre sono in gioco in questi trattamenti, vale a dire denti, ossa e tessuti molli.
Il messaggio che dovrebbe essere recepito dai colleghi odontoiatri è quindi duplice: da un lato, cioè, i parametri di estetica del viso che vengono comunemente utilizzati nella programmazione dei casi di chirurgia ortognatica (linea del sorriso, definizione del profilo, esposizione labio dentale ecc.) possono e devono valere anche nella programmazione di riabilitazioni implantoprotesiche di pazienti totalmente o parzialmente edentuli, per ottimizzare anche in questi casi l’armonia del volto, e dall’altro che il successo di un trattamento odontoiatrico (ortodontico o implantare) non può unicamente essere misurato dal “buco della serratura”, cioè guardando il paziente in bocca, ma deve essere valutato globalmente. Il paziente non va in giro con i suoi denti o con la sua lastra, ma con la sua faccia.
Dunque il ruolo più importante, sia in ambito ortognatico che implantoprotesico, è del chirurgo maxillo-facciale che, con il suo intervento, può modificare in modo anche drammatico l’estetica del volto?
Al contrario, il ruolo sia dell’ortodontista che del chirurgo implantare, oggi più che mai, è fondamentale. Infatti, per prima cosa, sia nella riabilitazione implantoprotesica che in chirurgia ortognatica, non è possibile raggiungere un buon risultato se non vi è un vero approccio multidisciplinare sin dall’inizio, con la discussione collegiale del caso e la definizione dei tempi e della priorità dei vari trattamenti specialistici. Ad esempio, se in chirurgia ortognatica l’ortodontista non finalizza in modo corretto la fase di decompenso degli incisivi, per quanto il chirurgo possa fare, non verrà mai ottenuto un buon rapporto labio-dentale sia superiormente che inferiormente. In implantologia spesso è presente nei pazienti totalmente edentuli un’atrofia del mascellare superiore con deficit della dimensione verticale anteriore e conseguente pseudoprognatismo per l’anterotazione mandibolare; di volta in volta, bisognerà valutare se è possibile correggere tale condizione soltanto con il confezionamento di una supporto protesico oppure con un intervento finalizzato al ripristino tridimensionale dei rapporti intermascellari. In altre parole, il collega odontoiatra deve sapere che anche i suoi trattamenti ortodontici o implantari condizionano nel bene e nel male l’estetica del III inferiore del viso, e in particolare dei tessuti molli periorali, che al termine di ogni terapia dovrebbero raggiungere un adeguato sostegno garantito sia dall’osso che dalla componente dentaria.
Nella pratica clinica, quindi, cosa significa affrontare un caso con un “Total Face Approach”?
Vuol dire essere consapevole che la richiesta del paziente parte dai denti (malocclusioni o edentulie), ma spesso sottintende anche e soprattutto motivazioni che vanno oltre l’elemento dentario. Cerchiamo di non essere attenti esclusivamente alla componente dentaria del caso; per dirla con Tiziano Testori, non guardiamo solo alla microestetica o miniestetica del dente, della protesi, della gengiva o della papilla, ma guardiamo anche e soprattutto alla macroestetica, a come cioè il lavoro odontoiatrico si inserisce nel viso del paziente. Questo approccio, che ovviamente è multispecialistico, oltre a migliorare la qualità del risultato finale, potrà essere un elemento distintivo del professionista che è in grado di offrire un servizio completo e differente al suo paziente. In ogni trattamento odontoiatrico ci sono dei risvolti di estetica, non solo dentaria, ma anche facciale, importantissimi che devono essere prima conosciuti e quindi previsti (Figg. 1a-i).
In altre parole, non è sufficiente – soprattutto nelle riabilitazioni più complesse – un bagaglio tecnico, ma bisogna programmare in dettaglio come l’estetica facciale cambierà?
Esatto, anche se spesso ai congressi vengono mostrate situazioni di edentulia brillantemente risolte con riabilitazioni implantoprotesiche non buone, ma addirittura ottime; però ci viene mostrato solo il dettaglio della protesi, tuttavia nella realtà bisogna vedere come quelle protesi si inseriscono nell’economia di quel viso. Ad esempio, bisogna prevedere se il sostegno protesico dei tessuti molli del labbro è corretto o deficitario, oppure se la linea del sorriso consente una buona esposizione labio-dentale che normalmente al sorriso scopre i denti incisivi fino a far vedere il colletto, oppure se permane un antiestetico sorriso gengivale o al contrario un’ipoesposizione dentaria. La stessa cosa vale in ortodonzia, quando spesso vengono discussi casi di malocclusioni ottimamente risolti, ma mostrando soltanto una documentazione fotografica dei rapporti occlusali finali, senza una visione del volto in toto.
Nelle edentulie totali, o quasi totali, e nelle malocclusioni suggerisce sempre la necessità di un approccio multidisciplinare?
Direi che questo oggi dovrebbe essere il gold standard, perché esistono per definizione competenze diverse che devono integrarsi (implantoprotesiche, chirurgiche, maxillo-facciali, ortognatodontiche) e il caso, sin dall’inizio, dovrebbe essere discusso con i vari specialisti che, senza desiderio di prevaricare, ma con il giusto spirito di gruppo e nel pieno rispetto delle rispettive competenze, possono raggiungere risultati fino a qualche anno fa impensati, anche nei casi apparentemente più “disperati”.
Ma tutto questo accade veramente nella realtà clinica o è solo un sogno ancora difficile da realizzare?
No, è già realtà. Abbiamo creato sul campo un team multidisciplinare che sempre si è confrontato nella discussione di ogni singolo caso, e io personalmente posso dire di aver imparato molto dalla collaborazione con colleghi implantologi e ortodontisti. Spero che loro possano affermare di avere a loro volta imparato da me qualcosa di utile per la loro professione. Secondo me, infatti, il messaggio finale dovrà essere proprio questo: nessuno da solo può ottenere il massimo, ma insieme, parafrasando il presidente Obama; «Yes, we can».
***
Dott.ssa Giovanna Perrotti, responsabile del Reparto di Ortognatodonzia prechirurgica presso l’Università degli Studi di Milano, Dipartimento di Tecnologie per la Salute, I.R.C.C.S. Istituto ortopedico Galeazzi, Clinica odontoiatrica (Direttore: prof. R.L. Weinstein).
Qual è il punto di vista dell’ortodontista rispetto al Total Face Approach?
L’ortodonzia moderna è strettamente correlata con l’estetica del viso e l’armonia dei tessuti molli perilabiali. Basti pensare alle controversie rispetto alle estrazioni dentarie o all’incremento della chirurgia ortognatica con finalità estetiche. Il Total Face Approach è noto come protocollo multidisciplinare ai fini di una sistematica diagnostica che soddisfi le esigenze dell’ortodontista, del chirurgo maxillo-facciale e dell’implantologo protesista. Il workflow tipo dell’ortodonzia per la fase diagnostica, che comprende la cefalometria bidimensionale e tridimensionale, l’analisi dei modelli e l’analisi estetica dei tessuti molli, è riportato come protocollo per la fase diagnostica dei casi candidati alla chirurgia ortognatica e alle grandi riabilitazioni implantoprotesiche.
Qual è l’obiettivo del Corso di Ortodonzia prechirurgica e come si inserisce il Total Face Approach in questo ambito?
Il corso si propone di mostrare un moderno approccio alla gestione dei casi ortodontici candidati alla chirurgia ortognatica, sia con dentatura completa sia edentuli, per i quali è richiesta una valutazione della malocclusione su base scheletrica. Il protocollo Total Face Approach si avvale della diagnostica digitale tridimensionale. Il corso si propone di spiegare come l’ausilio della diagnostica tridimensionale sia ormai diventato strumento fondamentale per il riconoscimento e la classificazione delle anomali scheletriche e per la programmazione virtuale del piano di trattamento (Figg. 2a-d).
***
Prof. Tiziano Testori, responsabile del Reparto di Implantologia e Riabilitazione orale presso la Clinica odontoiatrica (Direttore: prof. R.L. Weinstein), I.R.C.C.S. Istituto ortopedico Galeazzi, Università degli Studi di Milano.
Si parla tanto di semplificazione e mininvasività. Qual è il suo punto di vista?
La semplificazione dei protocolli clinici, unita a una riduzione dell’invasività del trattamento, è ormai da tempo una realtà clinica in implantologia.
Questi due importanti obiettivi devono però essere contestualizzati nella condizione clinica di ogni singolo paziente e non devono essere l’alibi per trattamenti parziali o incompleti. Una valutazione costi/benefici deve essere parte integrante dell’analisi globale del paziente; la mininvasività come obiettivo assoluto non può esistere in medicina, potrebbe essere solo un concetto sofisticato di marketing per attrarre paziente o giustificare l’incapacità di eseguire alcuni interventi chirurgici richiesti dalla condizione clinica del paziente.
Quali sono le principali alternative terapeutiche alle ricostruzioni ossee?
Un’attenta valutazione delle alternative terapeutiche nel settore latero-posteriore del mascellare permette in molti casi di evitare interventi più invasivi senza ridurre la percentuale di successo implantare. Nella ricostruzione del mascellare, in caso di atrofie monolaterali o bilaterali in pazienti parzialmente o totalmente edentuli, esistono alcune alternative terapeutiche che devono essere prese in considerazione; infatti, un insufficiente volume osseo nei settori latero-posteriori non rappresenta di per sé l’indicazione a eseguire interventi di ricostruzione ossea. Un’attenta valutazione delle possibili alternative rappresenta un’opzione terapeutica in tutti i pazienti che, per problemi di medicina generale, patologie presenti a livello del seno mascellare, età avanzata o per motivazioni psicologiche, non possono sottoporsi a un intervento chirurgico più invasivo quale l’elevazione del seno mascellare. Nei pazienti che presentano la mancanza dei denti posteriori bisogna valutare con attenzione che vi sia l’indicazione funzionale e/o estetica che giustifichi l’atto terapeutico, tenendo conto delle richieste del paziente che possono essere sia funzionali che estetiche. Un ulteriore parametro da considerare nella scelta di un trattamento alternativo è rappresentato dalla minore complessità della tecnica chirurgica, che consente di ridurre la morbilità, l’insorgenza di complicanze e un postoperatorio più rapido.
Un’attenta valutazione delle procedure alternative tende a ridurre il numero di indicazioni per procedure complesse e invasive, come il rialzo di seno o innesti ossei. In relazione alla condizione clinica, le alternative terapeutiche a un rialzo sinusale sono fondamentalmente quattro:
– impianti corti (Figg. 3a, b);
– impianti pre e post-sinusali;
– impianti inclinati in senso mesio-distale (Figg. 4a-g; Fig. 5; Fig. 6);
– impianti con cantilever distale.
Un’attenta valutazione delle alternative terapeutiche nel settore latero-posteriore del mascellare permette, in molti casi, di evitare interventi più invasivi senza ridurre la percentuale di successo implantare.
embedImagecenter("Imagecenter_1_1612",1612, "large");
L'articolo è stato pubblicato su Implant Tribune Italian Edition, marzo 2015.
Dental Tribune intervista Aldo Bruno Giannì, Giovanna Perrotti e Tiziano Testori.
E’ il terzo anno che l’AIO porta l’eccellenza dell’Odontoiatria Italiana a New York. Quest’anno addirittura raddoppia il ...
LONDRA, Gran Bretagna: domani il Regno Unito dovrà decidere se rimanere o lasciare l’Unione Europea: se da un lato l’uscita potrebbe ...
Cristina Parodi, piemontese di origine, ha presentato lo scorso 8 Novembre all’Auditorium di Torino Lingotto, di fronte a 1200 partecipanti, il meeting ...
BOSTON, USA: Circa 120 partecipanti provenienti da 27 Paesi si sono riuniti a Boston dal 16 al 18 giugno per un momento storico nell’odontoiatria ...
Da una parte i maghi del colore, dall’altra quelli della tecnologia, si potrebbe rappresentare così – forse un po’ ...
Nel nuovo numero di “A scuola di salute” le indicazioni su come comportarsi quando si è in presenza di infezioni da streptococco. Un tempo ...
Align lancia un programma dedicato ai membri ANDI che comprende una serie di moduli formativi per accrescere le competenze cliniche nella terapia con ...
Sono stati annunciati i vincitori dei due premi nell’ambito della ricerca, conferiti ogni anno dall’Associazione Europea di Osteointegrazione ...
Live webinar
lun. 15 giugno 2026
17:00 (CET) Rome
Dr. Cristian Scognamiglio, Dr. Alessandro Perucchi
Live webinar
mar. 16 giugno 2026
16:00 (CET) Rome
Elke Schilling Dentalhygienikerin, B.A. Medical Care Management
Live webinar
mer. 17 giugno 2026
1:00 (CET) Rome
Prof. Dr. Wael Att, Dr. Robert A. Levine DDS, FCPP, FISPPS, AOD, Dr. Victor Astolfi Gonzalez-Mogena ITI Scholar Columbia
Live webinar
mer. 17 giugno 2026
14:00 (CET) Rome
Live webinar
mer. 17 giugno 2026
18:00 (CET) Rome
Dr. Roy Samuelsson, Dr. Robert Gottlander DDS
Live webinar
gio. 18 giugno 2026
1:30 (CET) Rome
Live webinar
gio. 18 giugno 2026
17:00 (CET) Rome
Dr. Maximiliano Cacciacane Garcia



 Austria / Österreich
Austria / Österreich
 Bosnia ed Erzegovina / Босна и Херцеговина
Bosnia ed Erzegovina / Босна и Херцеговина
 Bulgaria / България
Bulgaria / България
 Croazia / Hrvatska
Croazia / Hrvatska
 Repubblica Ceca e Slovacchia / Česká republika & Slovensko
Repubblica Ceca e Slovacchia / Česká republika & Slovensko
 Francia / France
Francia / France
 Germania / Deutschland
Germania / Deutschland
 Grecia / ΕΛΛΑΔΑ
Grecia / ΕΛΛΑΔΑ
 Ungheria / Hungary
Ungheria / Hungary
 Italia / Italia
Italia / Italia
 Paesi Bassi / Nederland
Paesi Bassi / Nederland
 nordisch / Nordic
nordisch / Nordic
 Polonia / Polska
Polonia / Polska
 Portogallo / Portugal
Portogallo / Portugal
 Romania e Moldavia / România & Moldova
Romania e Moldavia / România & Moldova
 Slovenia / Slovenija
Slovenia / Slovenija
 Serbia e Montenegro / Србија и Црна Гора
Serbia e Montenegro / Србија и Црна Гора
 Spagna / España
Spagna / España
 Svizzera / Schweiz
Svizzera / Schweiz
 Turchia / Türkiye
Turchia / Türkiye
 Gran Bretagna e Irlanda / UK & Ireland
Gran Bretagna e Irlanda / UK & Ireland
 Internazionale / International
Internazionale / International
 Brasile / Brasil
Brasile / Brasil
 Canada / Canada
Canada / Canada
 America Latina / Latinoamérica
America Latina / Latinoamérica
 USA / USA
USA / USA
 Cina / 中国
Cina / 中国
 India / भारत गणराज्य
India / भारत गणराज्य
 Pakistan / Pākistān
Pakistan / Pākistān
 Vietnam / Việt Nam
Vietnam / Việt Nam
 ASEAN / ASEAN
ASEAN / ASEAN
 Israel / מְדִינַת יִשְׂרָאֵל
Israel / מְדִינַת יִשְׂרָאֵל
 Algeria, Marocco e Tunisia / الجزائر والمغرب وتونس
Algeria, Marocco e Tunisia / الجزائر والمغرب وتونس
 Medio Oriente / Middle East
Medio Oriente / Middle East

To post a reply please login or register